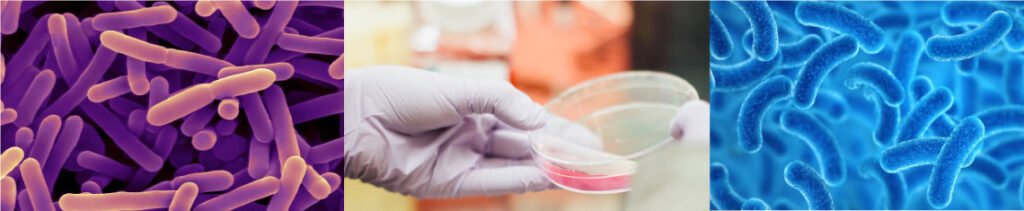

Los probióticos prometen ser la solución para diferentes problemas digestivos como el colon irritable, las úlceras y el reflujo, entre muchos otros.


Es importante saber que las bacterias probióticas son los microorganismos más importantes para mantener en equilibrio nuestra salud digestiva.
Existen muchos tipos de estas bacterias, pero todas tienen funcionalidades diferentes, por tanto hay que conocer detalladamente su actividad bioactiva para llegar al efecto deseado. Estas bacterias deben ingresar al organismo en altísimas cantidades de billones por día, para que prometan su eficacia; mantenerlas vivas y en perfecto estado, depende de alimentarlas con fibras especializadas llamadas prebióticas para que puedan nutrirse.
¿Cuales tipos de probióticos son los adecuados?
Hay dos tipos de probióticos, los de origen bacteriano y las levaduras. En el primer grupo encontramos principalmente especies de lactobacilos y bifidobacterias. Los lactobacilos se encuentran en el sistema digestivo, urinario y genital y en alimentos en especial los yogures.
Su función se centra principalmente en el tracto intestinal. Los lactobacilos ayudan a descomponer la comida y apoyan la absorción de los nutrientes.
En segundo lugar, están las bifidobacterias. Este tipo de microorganismos vive en la flora bacteriana del intestino, pero también se pueden encontrar en alimentos fermentados.
Por último, se encuentran los probióticos que no son de origen bacteriano, sino que están compuestos por levaduras que estan compuestas por diversos tipos de hongos causados por la fermentación.
Los probióticos pueden clasificarse de acuerdo a la diversidad de microorganismos probióticos que se componen de la siguiente manera:
Monocepa: contienen una cepa de una determinada especie de probiótico. Ejemplo: Lactobacillus acidophilus NCFM.
Multicepa: contienen más de una cepa de la misma especie o especies de probióticos que pueden estar muy relacionadas. Ejemplo: Lactobacillus acidophilus NCFM, Lactobacillus rhamnosus (GG ATCC 53103), Lactobasillus gasseri (OLL2716).
Multiespecie: contienen cepas de diferentes especies de probióticos y que pertenecen a uno o a más géneros. Ejemplo: Lactobacillus acidophilus NCFM, Lactobacillus rhamnosus (GG ATCC 53103), Lactobasillus gasseri (OLL2716), Bacillus Coagulans y Bifidobacterium Infantis.
Plenn Digest® es altamente beneficioso puesto que está diseñado con microorganismos multiespecie, para una mayor amplitud de colonizar el sistema digestivo, buscando un mayor balance y una simbiosis de amplio expectro en nuestro organismo.
Unidades formadoras de colonias (billones)
Un producto probiótico debe contener miles de millones o billones de unidades formadoras de colonias, llamadas UFC. Expertos en el campo de los probióticos sugieren que estos deben tener una concentración mínima diaria de 106 (un millón) UFC por mililitro o gramo de producto.
Propiedades:
- Antibacterianas.
- Cicatrización intestinal.
- Intervienen en la micro inflamación intestinal
- Disminución del dolor abdominal y la inflamación.
- Disminuyen la dispepsia funcional, respaldando la sensación de llenura y la quemazón.
- Previene procesos de diarrea.
- Disminución de los gases.
- Apoya los procesos frente al estreñimiento
- Acidez y reflujo gastroesofágico.
- Potencializan la absorción de los nutrientes.
- Respaldan al sistema inmunológico.
- Prebiotics and probiotics: are they functional foods? Marcel B Roberfroid. Downloaded from https://academic.oup.com/ajcn/article/71/6/1682S/4729644 by guest on 13 September 2021. Fecal Recovery in Humans of Viable Bifidobacterium sp Ingested in Fermented Milk. Yoram Bouhnik, Philippe Pochart, Philippe Marteau, Guillaume Arlet, Isabelle Goderel, and Jean Claude Rambaud. Uniti: de Recherches sur les Fonctions Intestinales, le MQtabolisme et la Nutrition, INSERM U290, Hdpital Saint Lazare, Paris; Dbpartement de Microbiologic-Immunologie, Uniti: de Formation et de Recherche des Sciences Pharmaceutiaues, Universiti! Paris XI, Chdtenay-Malabry; and Service de BactCriologie et de Virologie, HBpital Saint-Louis, Paris, France.
- Terpou y colaboradores (2019). Probiotics in food systems: Significance and emerging strategies towards improved viability and delivery of enhanced beneficial value. Nutrients, 11(7), 1591.
- Sniffen y colaboradores (2019). Choosing an appropriate probiotic product for your patient: An evidence-based practical guide. PLoS ONE, 13(12): e0209205.
- Timmerman y colaboradores (2004). Monostrain, multistrain and multispecies probiotics-A comparison of functionality and efficacy. International Journal of Food Microbiology, 96(3), 219-233.
- Lactobacillus acidophilus is a probiotic bacteria. Research suggests that consuming probiotics can be good for digestion and general health. Role of the gut microbiota in nutrition and health. BMJ: first published as 10.1136/bmj.k2179 on 13 June 2018. Downloaded from http://www.bmj.com/ on 13 September 2021 by guest.
-Efficacy and safety of Bacillus coagulans LBSC in irritable bowel syndrome: Anil Kumar Gupta, PhD, Chiranjit Maity, PhD http://dx.doi.org/10.1097/MD.000000000002364.
- Randomised clinical trial: Bifidobacterium lactis NCC2818probiotic vs placebo, and impact on gut transit time, symptoms, and gut microbiology in chronic constipation. Eirini Dimidi Ausra Zdanaviciene Stephanos Christodoulides, Shiva Taheri Petra Louis Peter I, Duncan Nashmil Emami Rafael Crabbé, Antonio de Castro, Peter McLean, Gabriela E. Bergonzelli, Kevin Whelan, Mark Scott. DOI: 10.1111/apt.15073. 3 November 2018. - Efficacy of Bifidobacterium infantis 35624 in patients with irritable bowel syndrome: a meta-analysis: https://doi.org/10.1080/03007995.2017.1292230.